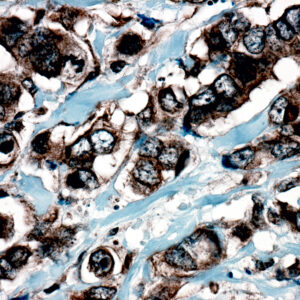
Anti-Catenin Delta 1 (P120)
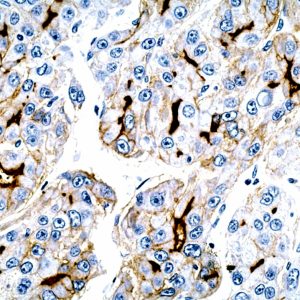
AR009
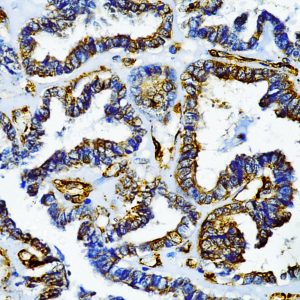
AN926
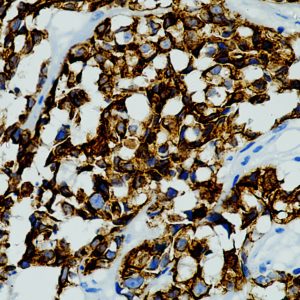
AN892
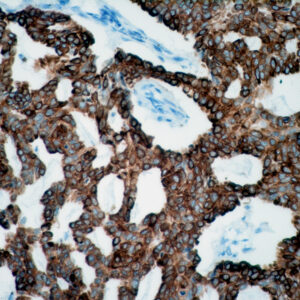
Anti-Cytokeratin 15

C
Showing 41–60 of 234 resultsSorted by latest
-
Anti-Catenin Delta 1 (P120)
Price range: $325.00 through $935.00 Select options This product has multiple variants. The options may be chosen on the product page -

Anti-CD23
Price range: $250.00 through $1,289.00 Select options This product has multiple variants. The options may be chosen on the product page -

Anti-Cyclin D1
Price range: $203.00 through $941.00 Select options This product has multiple variants. The options may be chosen on the product page -

Anti-Calretinin
Price range: $400.00 through $1,105.00 Select options This product has multiple variants. The options may be chosen on the product page -
Anti-Carcinoembryonic Antigen (CEA)
Price range: $250.00 through $1,125.00 Select options This product has multiple variants. The options may be chosen on the product page -

Anti- c-Myc
Price range: $269.00 through $1,135.00 Select options This product has multiple variants. The options may be chosen on the product page -

Anti-COX2, Clone COX2/3320R
Price range: $269.00 through $1,319.00 Select options This product has multiple variants. The options may be chosen on the product page -

Anti-Cyclin D1, Clone E3P5S
Price range: $269.00 through $1,205.00 Select options This product has multiple variants. The options may be chosen on the product page -

Anti-CD21, Clone RM372
Price range: $269.00 through $1,235.00 Select options This product has multiple variants. The options may be chosen on the product page -

Anti-CD23
Price range: $269.00 through $2,149.00 Select options This product has multiple variants. The options may be chosen on the product page -

Anti-CD30
Price range: $439.00 through $1,170.00 Select options This product has multiple variants. The options may be chosen on the product page -

Anti-Cytokeratin 16
Price range: $375.00 through $959.00 Select options This product has multiple variants. The options may be chosen on the product page -
Anti-Calcitonin
Price range: $410.00 through $1,320.00 Select options This product has multiple variants. The options may be chosen on the product page -

Anti-CDK9
Read more -

Anti-CDK9
Price range: $250.00 through $1,245.00 Select options This product has multiple variants. The options may be chosen on the product page -

Anti-CDK2
Read more -

Anti-CDK2
Price range: $250.00 through $1,329.00 Select options This product has multiple variants. The options may be chosen on the product page -
Anti-Cytokeratin 5&6
Price range: $269.00 through $1,729.00 Select options This product has multiple variants. The options may be chosen on the product page -
Anti-Cytokeratin 15
Price range: $250.00 through $1,199.00 Select options This product has multiple variants. The options may be chosen on the product page -

Anti-Cyclin E1
Price range: $250.00 through $1,265.00 Select options This product has multiple variants. The options may be chosen on the product page

